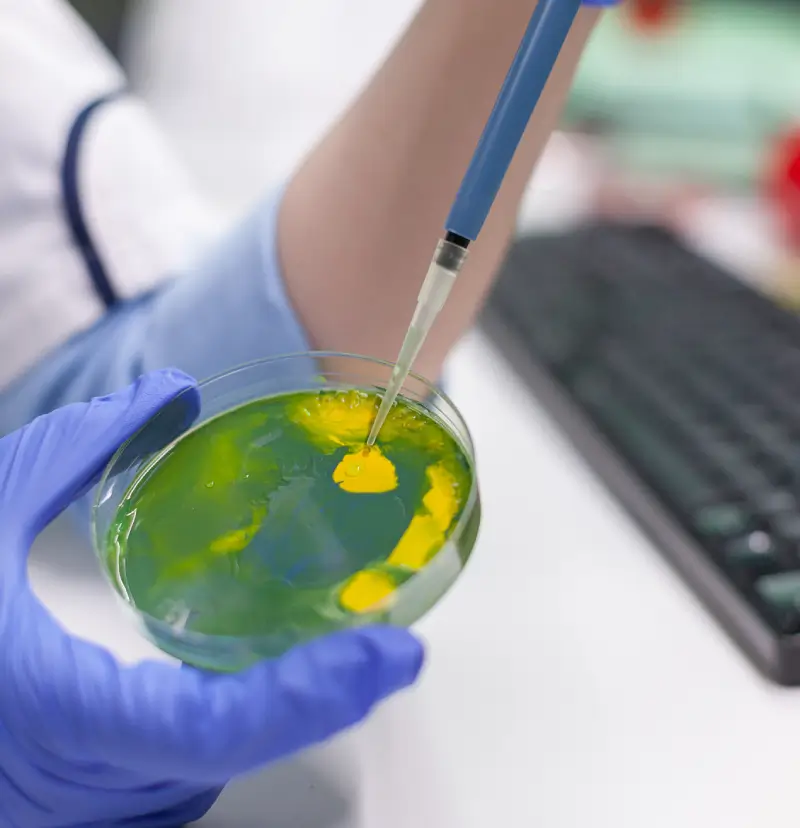

Genetic modification represents a leap in biotechnological innovation, where foreign DNA is intricately inserted into a standard cell's nucleus. This action creates a merger between the introduced genetic sequence and the host organism's DNA, crafting what is commonly known as a genetically modified organism (GMO). The implications of such modifications are far-reaching, with potential impacts on crop resilience, nutritional profiles, and ecological dynamics.
Detecting and analyzing these genetic alterations is essential for safety and compliance with regulatory standards. Genetic analysis is an important part of this process, utilizing a suite of molecular techniques designed to reveal the presence of transgenic DNA within a sample. The foundation of this analysis is the Polymerase Chain Reaction (PCR), a technique highly valued for its accuracy and sensitivity.
The PCR method is essential in genetics, allowing for the significant increase of specific DNA segments. This amplification allows for the meticulous examination of genetic modifications in organisms, which could otherwise go undetected due to their minuscule quantity in a sample. PCR employs a sequence-specific approach that targets the inserted DNA, ensuring the detection of the GMO attributes is accurate and relevant.

PCR-based GMO detection methods can be designed to detect all relevant transgenic sequences based on the desired information.

GMO detection methods based on genetic analysis offer precise and adaptable results that are useful across various sample types. This technique continually evolves, improving accuracy and efficiency for widespread application in quality control within the food sectors.
The PCR (DNA analysis) test method can detect commercialized GMOs, is effective with a broad array of sample types (seed, grain, processed ingredients, finished products), and can provide definitive quantification of GMOs since analysis is performed directly at the DNA level. For these reasons, PCR is one of the standard GMO test methods used in GMO testing laboratories to verify trade contracts and ensure regulatory compliance.

Choose FoodChain ID Testing for your GMO testing to benefit from our ISO 17025 accredited lab, recognized for technical excellence and precise results.
With our vast experience in GMO analysis, we provide customized protocols and expert guidance for assured compliance and product integrity, all wrapped in a service you can trust.
Genetic analysis in GMO testing is a method for identifying and understanding genetic modifications in organisms. This typically involves PCR techniques to detect unique DNA sequences indicative of genetic alterations.
PCR is preferred for its high sensitivity and precision. It can detect genetic modifications even in highly processed products, ensuring regulatory compliance and consumer transparency.
It verifies non-GMO claims, provides traceability of GMOs throughout the supply chain, and upholds strict quality control to adhere to global regulatory standards and ensure the safety and authenticity of food products.
Genetic modifications can impact crop resilience, nutritional profiles, and ecological dynamics, making detecting and analyzing these changes critical for safety and compliance.
Yes, PCR can detect all commercialized GMOs and is effective across a wide range of sample types, providing definitive quantification of GMOs.
A broad-spectrum GMO test uses PCR to target common viral or bacterial elements in transgenes that are not specific to one GM crop/event to screen for the presence of GMOs.
An event-specific GMO test is a PCR assay to identify unique genetic modifications to a specific GMO event.
A combination of tests is most efficient for quantifying GMO levels in a sample, especially when specific information about the GM crop needs to be identified.
An ISO 17025 accredited lab like FoodChain ID Testing ensures technical excellence, precise results, and compliance with high-quality standards in GMO analysis.
FoodChain ID Testing offers extensive experience in GMO analysis with customized testing protocols and expert guidance, ensuring compliance, product integrity, and trusted results.
© 2024 FoodChain ID | Privacy Policy | Terms Of Use | Internet Marketing by Authority Solutions®